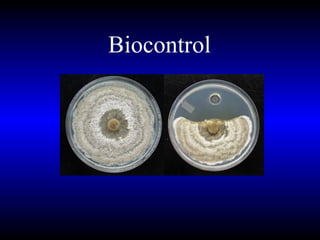
Biocontrol
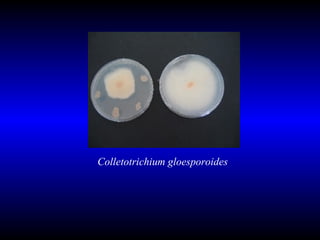
Colletotrichium gloesporoides
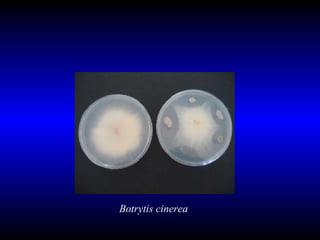
Botrytis cinerea
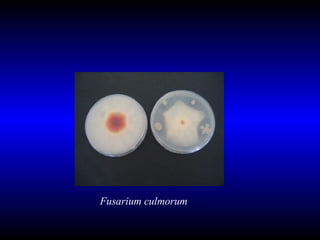
Fusarium culmorum
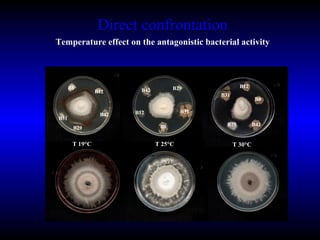
Direct confrontation Temperature effect on the antagonistic bacterial activity B31 B8 B29 B12 B42 B31 B12 B29 B42 B8 B8 B29 B42 B12 B31 T 19°C T 30°C T 25°C
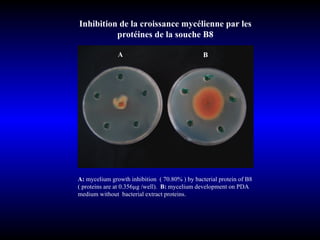
Inhibition de la croissance mycélienne par les protéines de la souche B8 A:  mycelium   growth inhibition  ( 70.80% ) by bacterial protein of B8 ( proteins are at 0.356µg /well).  B:  mycelium development on PDA  medium without  bacterial extract proteins. A B
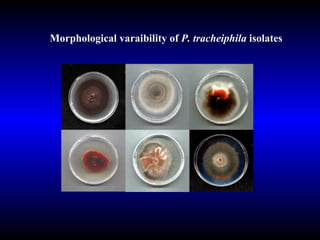
Morphological varaibility of  P. tracheiphila  isolates
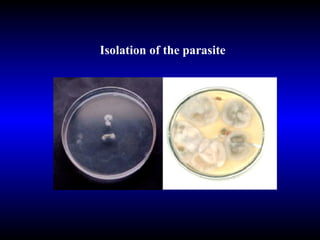
Isolation of the parasite

Phytopathology is the study of plant diseases caused by pathogens and physiological factors. The document discusses various plant pathogens like viruses, bacteria, fungi, nematodes and parasitic plants that cause different plant diseases. It also describes methods of disease control which include chemical treatments, biocontrol methods and developing resistant plant varieties through cultural practices and breeding.